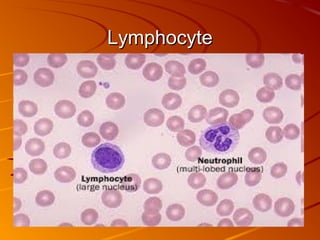
Lymphocyte

Blood is a vital fluid in the human body, comprising about five liters that transport oxygen, nutrients, and waste products. It consists of 55% plasma, which carries blood cells, and 45% cells, including red blood cells for oxygen transport and white blood cells for immune defense. Platelets are crucial for blood clotting and healing wounds, while the body can replace lost blood through bone marrow production or transfusions in case of significant blood loss.